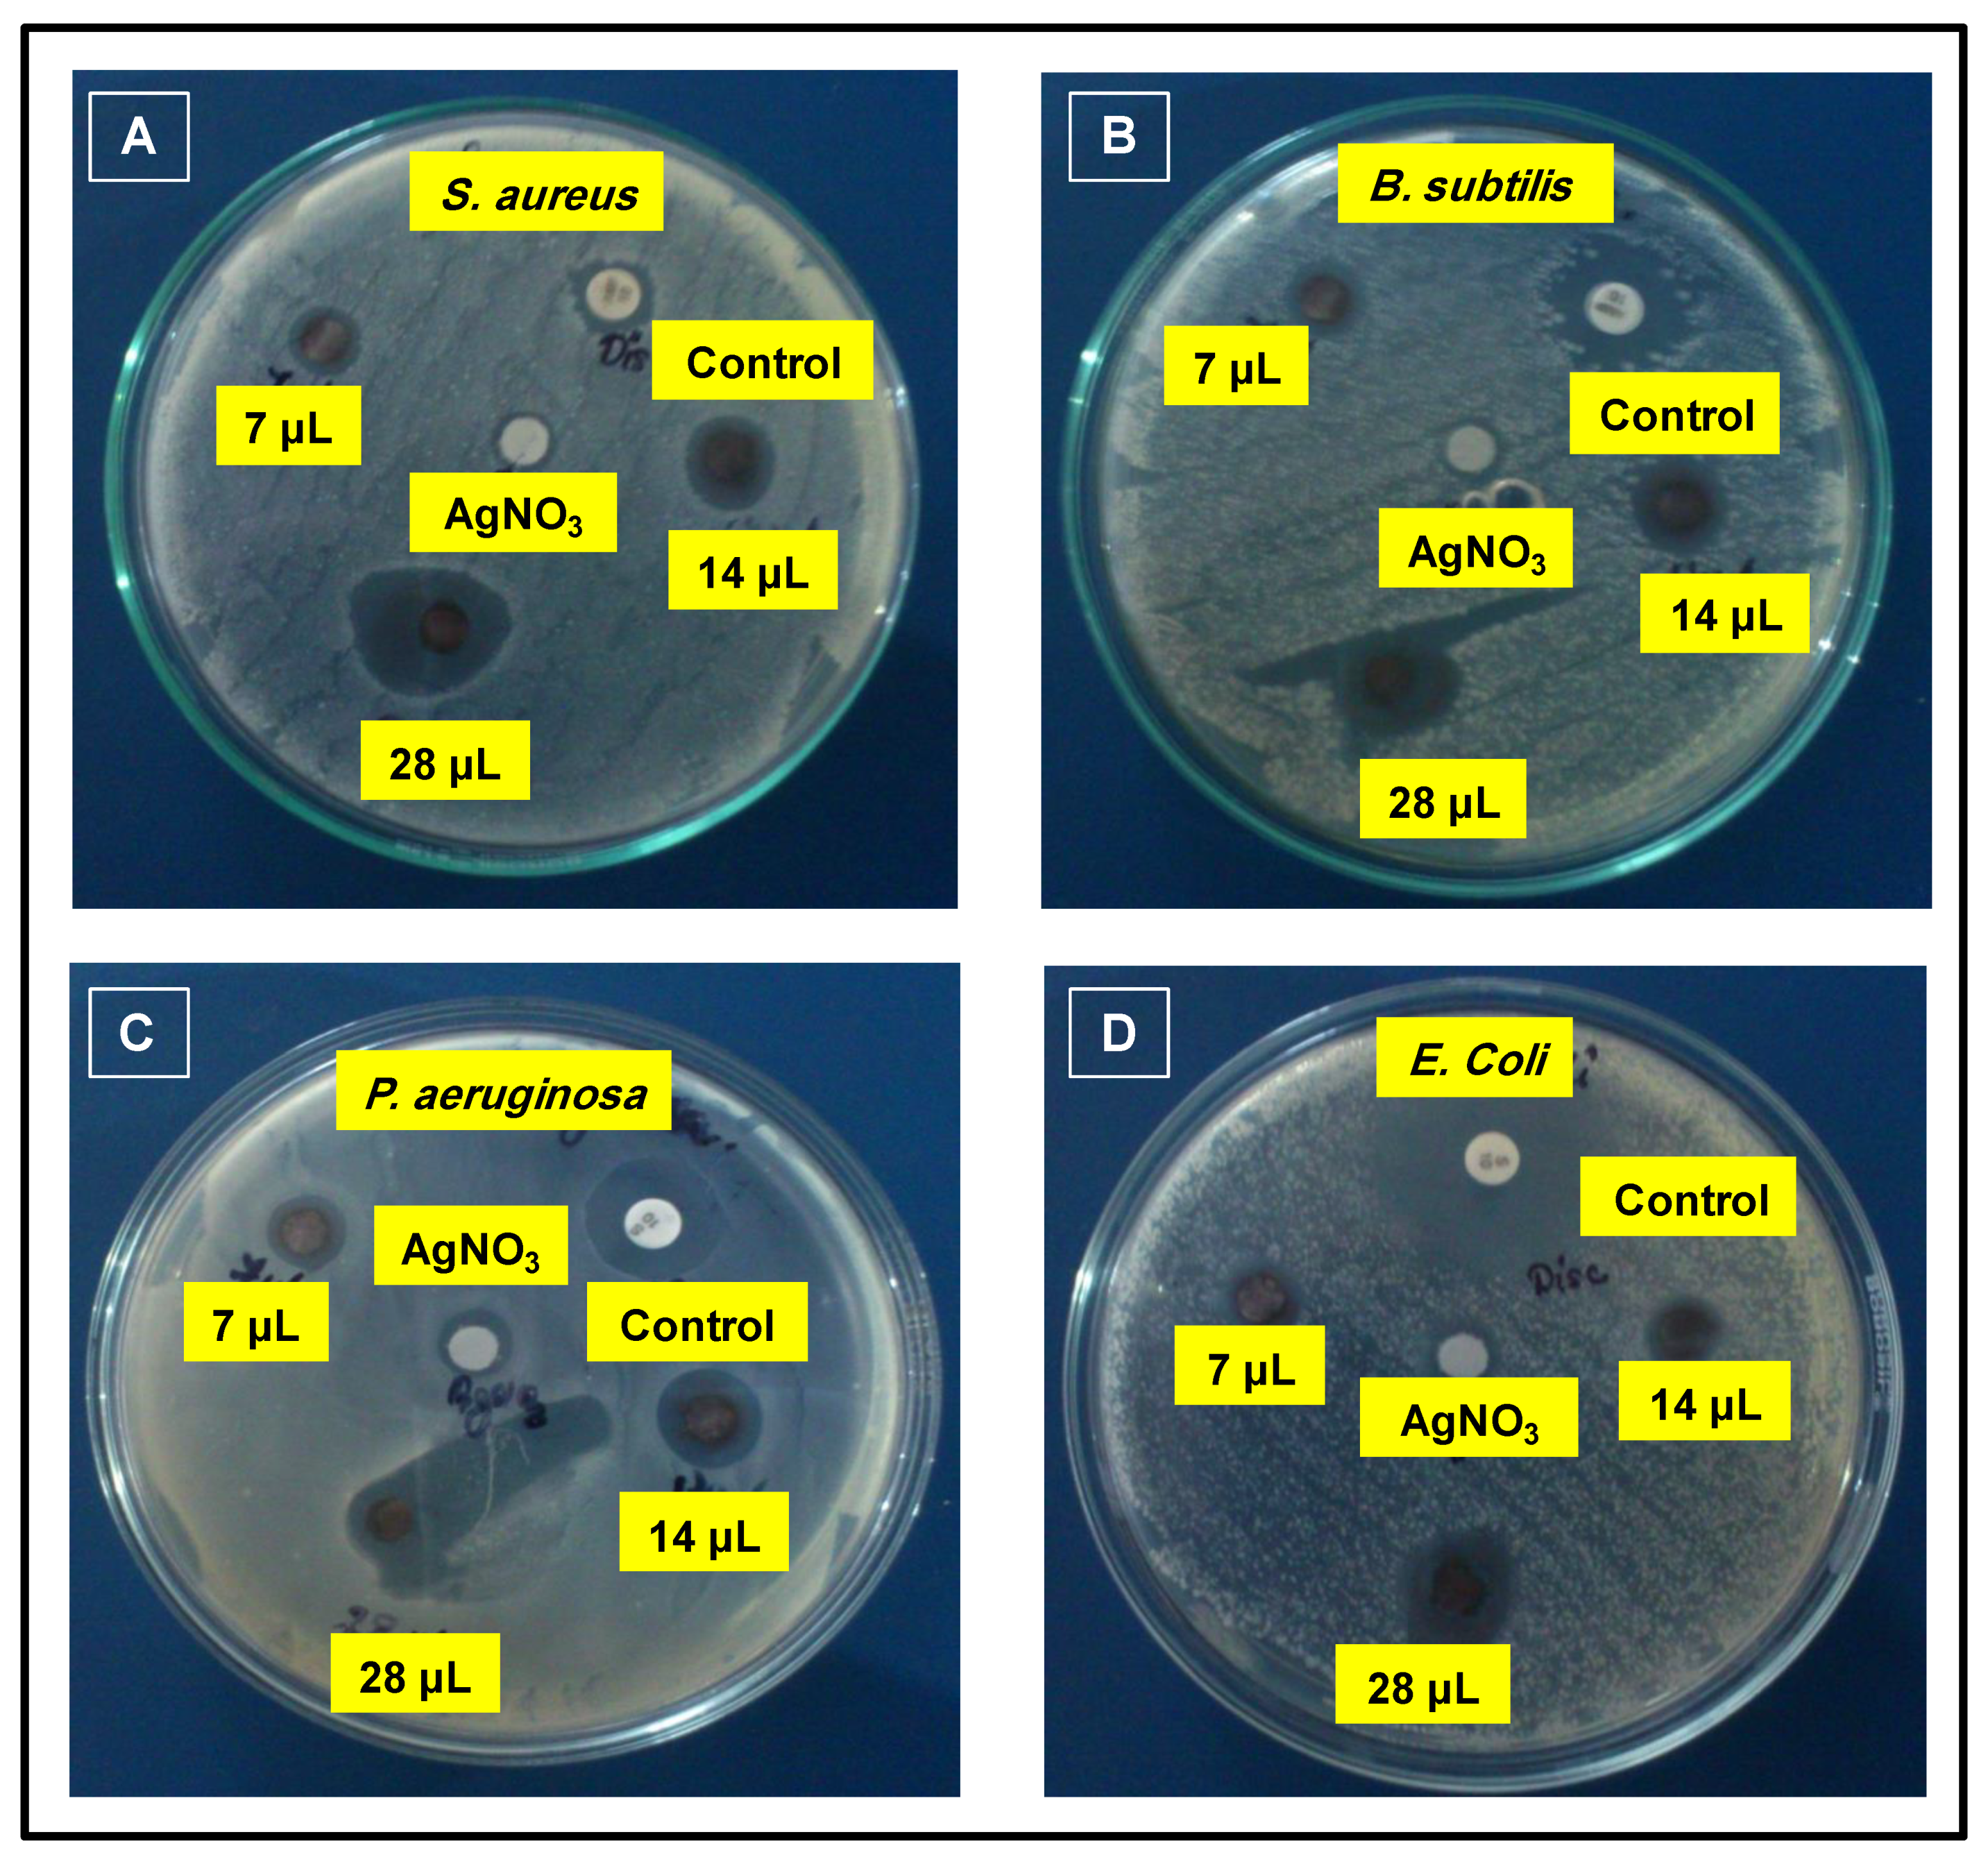
Sustainability 12 01484 g008 Sustainability 12 01484 g008
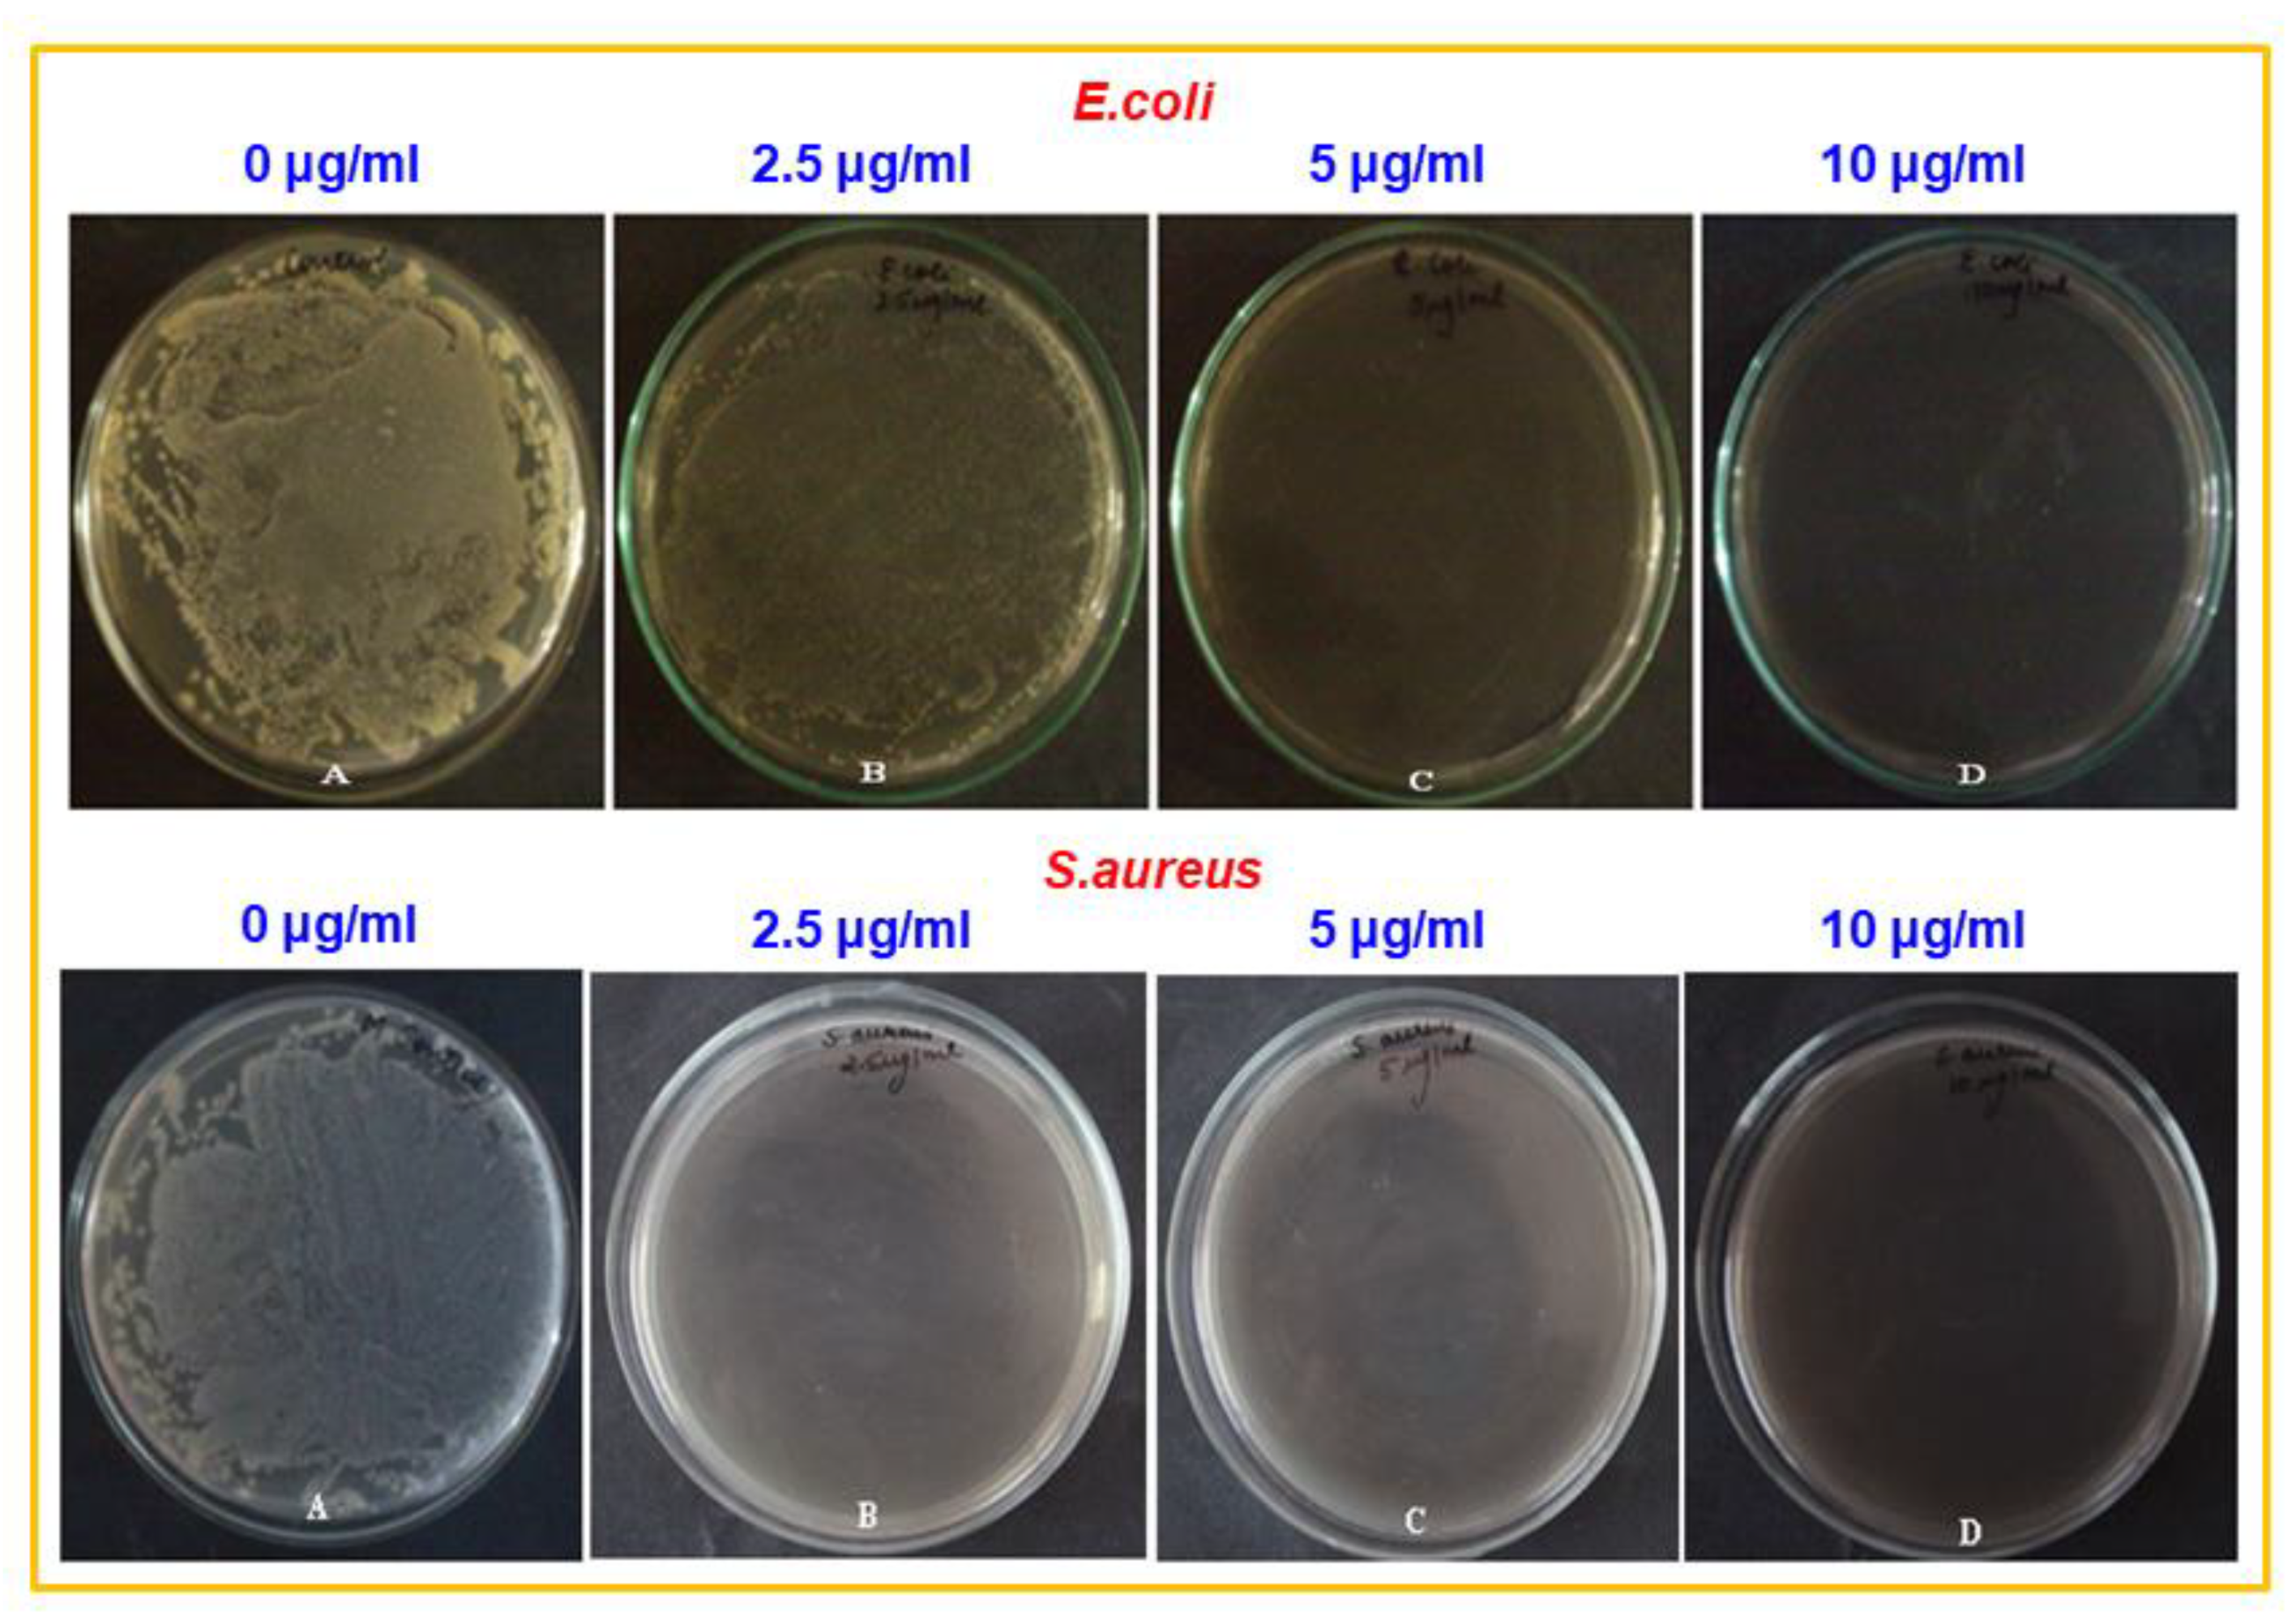
Sustainability 12 01484 g009 Sustainability 12 01484 g009

Study of Antibacterial Properties of Ziziphus mauritiana based Green Synthesized Silver Nanoparticles against Various Bacterial Strains
Abstract
1. Introduction
2. Experimental
2.1. Materials
2.2. Collection and Preparation of Z. mauritiana Leaves Extract
2.3. Leaves Extract Based Synthesis of Silver (Ag) Nanoparticles
2.4. Phytochemical Screening
2.4.1. Test for Alkaloids (Mayer’s Test)
2.4.2. Test for Flavonoids (Shinoda Test)
2.4.3. Test for Glycosides (Keller Killani Test)
2.4.4. Test for Phenols
2.4.5. Folin-Ciocalteu Method
2.4.6. Test for Saponins (Foam Test)
2.4.7. Test for Sterols (Liebermann-Burchard Test)
2.4.8. Test for Tannins
2.5. Characterization
2.6. Antibacterial Properties
2.6.1. Inoculums of Microorganism
2.6.2. Disc Diffusion Assay
2.6.3. Determination of Minimum Inhibitory Concentration (MIC)
3. Results and Discussion
3.1. UV-Vis Analysis
3.2. XRD Analysis
3.3. Preliminary Identification of Phytomolecules on the Surface of ZM-AgNPs
3.4. Antimicrobial Properties
4. Conclusions
Author Contributions
Funding
Acknowledgments
Conflicts of Interest
References
- Gao, J.; Gu, H.; Xu, B. Multifunctional Magnetic Nanoparticles: Design, Synthesis, and Biomedical Applications. Acc. Chem. Res. 2009, 42, 1097–1107. [Google Scholar] [CrossRef] [PubMed]
- Vinci, G.; Rapa, M. Noble Metal Nanoparticles Applications: Recent Trends in Food Control. Bioengineering 2019, 6, 10. [Google Scholar] [CrossRef] [PubMed]
- Ocsoy, I.; Tasdemir, D.; Mazicioglu, S.; Celik, C.; Katı, A.; Ulgen, F. Biomolecules incorporated metallic nanoparticles synthesis and their biomedical applications. Mater. Lett. 2018, 212, 45–50. [Google Scholar] [CrossRef]
- Khan, M.; Al-Marri, A.H.; Khan, M.; Mohri, N.; Adil, S.F.; Al-Warthan, A.; Siddiqui, M.R.H.; Alkhathlan, H.Z.; Berger, R.; Tremel, W.; et al. Pulicaria glutinosa plant extract: A green and eco-friendly reducing agent for the preparation of highly reduced graphene oxide. RSC Adv. 2014, 4, 24119–24125. [Google Scholar] [CrossRef]
- Chernousova, S.; Epple, M. ChemInform Abstract: Silver as Antibacterial Agent: Ion, Nanoparticle, and Metal. Angew. Chem. Int. Ed. 2013, 44, 1636–1653. [Google Scholar] [CrossRef]
- Franci, G.; Falanga, A.; Galdiero, S.; Palomba, L.; Rai, M.; Morelli, G.; Galdiero, S. Silver Nanoparticles as Potential Antibacterial Agents. Molecules 2015, 20, 8856–8874. [Google Scholar] [CrossRef]
- Rigo, C.; Ferroni, L.; Tocco, I.; Roman, M.; Munivrana, I.; Gardin, C.; Cairns, W.R.L.; Vindigni, V.; Azzena, B.; Barbante, C.; et al. Active Silver Nanoparticles for Wound Healing. Int. J. Mol. Sci. 2013, 14, 4817–4840. [Google Scholar] [CrossRef]
- Ho, C.H.; Odermatt, E.K.; Berndt, I.; Tiller, J.C. Long-term active antimicrobial coatings for surgical sutures based on silver nanoparticles and hyperbranched polylysine. J. Biomater. Sci. Polym. Ed. 2013, 24, 1589–1600. [Google Scholar] [CrossRef]
- Zhang, X.-F.; Liu, Z.; Shen, W.; Gurunathan, S. Silver Nanoparticles: Synthesis, Characterization, Properties, Applications, and Therapeutic Approaches. Int. J. Mol. Sci. 2016, 17, 1534. [Google Scholar] [CrossRef]
- MubarakAli, D.; Thajuddin, N.; Jeganathan, K.; Gunasekaran, M. Plant extract mediated synthesis of silver and gold nanoparticles and its antibacterial activity against clinically isolated pathogens. Colloids Surf. B Biointerfaces 2011, 85, 360–365. [Google Scholar] [CrossRef]
- Vasilev, K.; Cavallaro, A.; Zilm, P. Special Issue: Antibacterial Materials and Coatings. Molecules 2018, 23, 585. [Google Scholar] [CrossRef]
- Adil, S.F.; Assal, M.E.; Khan, M.; Al-Warthan, A.; Siddiqui, M.R.H.; Liz-Marzán, L.M. Biogenic synthesis of metallic nanoparticles and prospects toward green chemistry. Dalton Trans. 2015, 44, 9709–9717. [Google Scholar] [CrossRef]
- Shah, M.; Fawcett, D.; Sharma, S.; Tripathy, S.K.; Poinern, G. Green Synthesis of Metallic Nanoparticles via Biological Entities. Materials 2015, 8, 7278–7308. [Google Scholar] [CrossRef]
- Akhtar, M.S.; Panwar, J.; Yun, Y.-S. Biogenic Synthesis of Metallic Nanoparticles by Plant Extracts. ACS Sustain. Chem. Eng. 2013, 1, 591–602. [Google Scholar] [CrossRef]
- Khan, M.; Shaik, M.R.; Adil, S.F.; Khan, S.T.; Al-Warthan, A.A.; Siddiqui, M.R.H.; Tahir, M.N.; Tremel, W.; Siddiqui, R.H. Plant extracts as green reductants for the synthesis of silver nanoparticles: Lessons from chemical synthesis. Dalton Trans. 2018, 47, 11988–12010. [Google Scholar] [CrossRef]
- Nadagouda, M.N.; Varma, R.S. Green synthesis of silver and palladium nanoparticles at room temperature using coffee and tea extract. Green Chem. 2008, 10, 859. [Google Scholar] [CrossRef]
- Nishibuchi, M.; Chieng, B.W.; Loo, Y.Y.; Radu, S. Synthesis of silver nanoparticles by using tea leaf extract from Camellia Sinensis. Int. J. Nanomed. 2012, 7, 4263–4267. [Google Scholar] [CrossRef] [PubMed]
- Siddiqui, M.R.H.; Khan, M.; Khan, M.; Adil, S.F.; Tahir, M.N.; Tremel, W.; Alkhathlan, H.Z.; Al-Warthan, A. Green synthesis of silver nanoparticles mediated by Pulicaria glutinosa extract. Int. J. Nanomed. 2013, 8, 1507–1516. [Google Scholar] [CrossRef] [PubMed]
- Shaik, M.R.; Khan, M.; Kuniyil, M.; Kuniyil, M.; Alkhathlan, H.Z.; Siddiqui, M.R.H.; Shaik, J.P.; Ahamed, A.; Mahmood, A.; Khan, M.; et al. Plant-Extract-Assisted Green Synthesis of Silver Nanoparticles Using Origanum vulgare L. Extract and Their Microbicidal Activities. Sustainability 2018, 10, 913. [Google Scholar] [CrossRef]
- Parmar, P.; Bhatt, S.; Dhyani, S.; Jain, A. Phytochemical studies of the secondary metabolites of Ziziphus mauritiana Lam. Leaves. Int. J. Curr. Pharm. Res. 2012, 4, 153–155. [Google Scholar]
- Mahajan, R.T.; Chopda, M. Phyto-Pharmacology of Ziziphus jujuba Mill-A plant review. Pharmacogn. Rev. 2009, 3, 320. [Google Scholar]
- Choi, S.-H.; Ahn, J.-B.; Kozukue, N.; Levin, C.; Friedman, M. Distribution of Free Amino Acids, Flavonoids, Total Phenolics, and Antioxidative Activities of Jujube (Ziziphus jujuba) Fruits and Seeds Harvested from Plants Grown in Korea. J. Agric. Food Chem. 2011, 59, 6594–6604. [Google Scholar] [CrossRef]
- Gao, Q.-H.; Wu, C.-S.; Wang, M. The Jujube (Ziziphus Jujuba Mill.) Fruit: A Review of Current Knowledge of Fruit Composition and Health Benefits. J. Agric. Food Chem. 2013, 61, 3351–3363. [Google Scholar] [CrossRef] [PubMed]
- Sadeghi, B. Zizyphus mauritiana extract-mediated green and rapid synthesis of gold nanoparticles and its antibacterial activity. J. Nanostruct. Chem. 2015, 5, 265–273. [Google Scholar] [CrossRef]
- Padalia, H.; Chanda, S. Characterization, antifungal and cytotoxic evaluation of green synthesized zinc oxide nanoparticles using Ziziphus nummularia leaf extract. Artif. Cells Nanomed. Biotechnol. 2017, 45, 1751–1761. [Google Scholar] [CrossRef]
- Al-Bahrani, R.M.; Majeed, S.M.A.; Owaid, M.; Mohammed, A.B.; Rheem, D.A. Phyto-fabrication, characteristics and anticandidal effects of silver nanoparticles from leaves of Ziziphus mauritiana lam. Acta Pharm. Sci. 2018, 56, 85. [Google Scholar] [CrossRef]
- Saifuddin, N.; Wong, C.W.; Yasumira, A.A.N. Rapid Biosynthesis of Silver Nanoparticles Using Culture Supernatant of Bacteria with Microwave Irradiation. E-J. Chem. 2009, 6, 61–70. [Google Scholar] [CrossRef]
- Ansari, M.; Khan, H.; Khan, A.; Malik, A.; Sultan, A.; Shahid, M.; Shujatullah, F.; Azam, A. Evaluation of antibacterial activity of silver nanoparticles against MSSA and MSRA on isolates from skin infections. Biol. Med. 2011, 3, 141–146. [Google Scholar]
- Sathishkumar, G.; Gobinath, C.; Karpagam, K.; Hemamalini, V.; Kumpati, P.; Sivaramakrishnan, S. Phyto-synthesis of silver nanoscale particles using Morinda citrifolia L. and its inhibitory activity against human pathogens. Colloids Surf. B Biointerfaces 2012, 95, 235–240. [Google Scholar] [CrossRef]
- Smitha, S.; Nissamudeen, K.; Philip, D.; Gopchandran, K.; Gopalan, G.K. Studies on surface plasmon resonance and photoluminescence of silver nanoparticles. Spectrochim. Acta Part A Mol. Biomol. Spectrosc. 2008, 71, 186–190. [Google Scholar] [CrossRef]
- Singleton, V.L.; Orthofer, R.; Lamuela-Raventós, R.M. [14] Analysis of total phenols and other oxidation substrates and antioxidants by means of folin-ciocalteu reagent. Methods Enzymol. 1999, 299, 152–178. [Google Scholar]
- Kumar, V.; Yadav, S.C.; Yadav, S.K. Syzygium cumini leaf and seed extract mediated biosynthesis of silver nanoparticles and their characterization. J. Chem. Technol. Biotechnol. 2010, 85, 1301–1309. [Google Scholar] [CrossRef]
- Mittal, A.K.; Tripathy, D.; Choudhary, A.; Aili, P.K.; Chatterjee, A.; Singh, I.P.; Banerjee, U.C. Bio-synthesis of silver nanoparticles using Potentilla fulgens Wall. ex Hook. and its therapeutic evaluation as anticancer and antimicrobial agent. Mater. Sci. Eng. C 2015, 53, 120–127. [Google Scholar] [CrossRef] [PubMed]
- Hafsé, M.; Farah, A.; Benbrahim, K.F. Evaluation of the antibacterial activity and determination of polyphenols and flavonoids contents of Moroccan Coriaria myrtifolia extracts. Int. J. Pharm. Pharm. Sci. 2015, 7, 108–111. [Google Scholar]
- Warburton, E.; Norris, P.L.; Goenaga-Infante, H. Comparison of the capabilities of accelerated solvent extraction and sonication as extraction techniques for the quantification of kavalactones in Piper methysticum (Kava) roots by high performance liquid chromatography with ultra violet detection. Phytochem. Anal. 2007, 18, 98–102. [Google Scholar] [CrossRef]
- Shameli, K.; Bin Ahmad, M.; Zamanian, A.; Sangpour, P.; Shabanzadeh, P.; Abdollahi, Y.; Zargar, M. Green biosynthesis of silver nanoparticles using Curcuma longa tuber powder. Int. J. Nanomed. 2012, 7, 5603–5610. [Google Scholar] [CrossRef]
- Li, W.-R.; Xie, X.-B.; Shi, Q.-S.; Zeng, H.-Y.; You-Sheng, O.-Y.; Chen, Y.-B. Antibacterial activity and mechanism of silver nanoparticles on Escherichia coli. Appl. Microbiol. Biotechnol. 2010, 85, 1115–1122. [Google Scholar] [CrossRef]
- Phongtongpasuk, S.; Poadang, S.; Yongvanich, N. Environmental-friendly Method for Synthesis of Silver Nanoparticles from Dragon Fruit Peel Extract and their Antibacterial Activities. Energy Procedia 2016, 89, 239–247. [Google Scholar] [CrossRef]

| Zone of Inhibition (mm) | ||||||
|---|---|---|---|---|---|---|
| Bacterial Strains | Control | AgNO3 Solution | ZM-AgNPs | |||
| 7 μl | 14 μl | 28 μl | ||||
| Gram + ve | S. aureus (MTCC No. 96) | 8 | 3 | 8 | 16 | 28 |
| B. subtilus (MTCC No. 441) | 26 | 4 | 10 | 18 | 26 | |
| Gram − ve | P. aeruginosa (MTCC No. 424) | 26 | 4 | 9 | 19 | 21 |
| E. coli (MTCC No. 1722) | 28 | 4 | 8 | 12 | 22 | |
© 2020 by the authors. Licensee MDPI, Basel, Switzerland. This article is an open access article distributed under the terms and conditions of the Creative Commons Attribution (CC BY) license (http://creativecommons.org/licenses/by/4.0/).
Share and Cite
Asimuddin, M.; Shaik, M.R.; Fathima, N.; Afreen, M.S.; Adil, S.F.; Rafiq H. Siddiqui, M.; Jamil, K.; Khan, M. Study of Antibacterial Properties of Ziziphus mauritiana based Green Synthesized Silver Nanoparticles against Various Bacterial Strains. Sustainability 2020, 12, 1484. https://doi.org/10.3390/su12041484
Asimuddin M, Shaik MR, Fathima N, Afreen MS, Adil SF, Rafiq H. Siddiqui M, Jamil K, Khan M. Study of Antibacterial Properties of Ziziphus mauritiana based Green Synthesized Silver Nanoparticles against Various Bacterial Strains. Sustainability. 2020; 12(4):1484. https://doi.org/10.3390/su12041484
Chicago/Turabian StyleAsimuddin, M., Mohammed Rafi Shaik, Neeshat Fathima, M. Shaistha Afreen, Syed Farooq Adil, Mohammed Rafiq H. Siddiqui, Kaiser Jamil, and Mujeeb Khan. 2020. "Study of Antibacterial Properties of Ziziphus mauritiana based Green Synthesized Silver Nanoparticles against Various Bacterial Strains" Sustainability 12, no. 4: 1484. https://doi.org/10.3390/su12041484
APA StyleAsimuddin, M., Shaik, M. R., Fathima, N., Afreen, M. S., Adil, S. F., Rafiq H. Siddiqui, M., Jamil, K., & Khan, M. (2020). Study of Antibacterial Properties of Ziziphus mauritiana based Green Synthesized Silver Nanoparticles against Various Bacterial Strains. Sustainability, 12(4), 1484. https://doi.org/10.3390/su12041484

